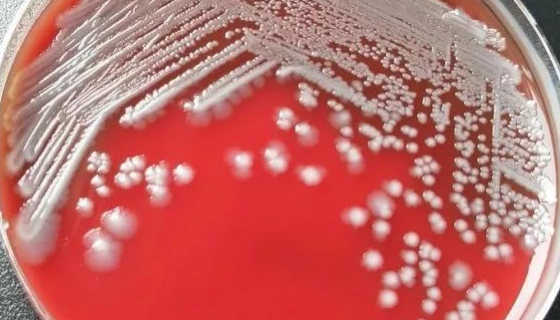
动物源性食品中细菌的检测——志贺氏菌
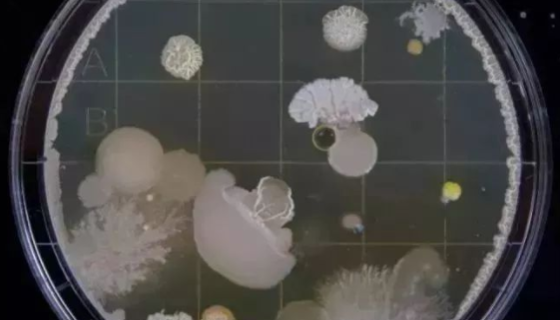
ATCC 33270 微小小单胞菌的培养与保存！

动物源性食品中细菌的检测——志贺氏菌
志贺氏菌属(Shigella)是一类革兰氏阴性杆菌,是人类细...

牛血清白蛋白的制备与制剂及检测方法!
牛血清白蛋白在牛血液中约占50%,血液中的牛血清白蛋白主要起...

卡纳霉素链霉菌的特点与优势及冻干管打管说明!
卡纳霉素链霉菌用于实验和科研检测用,属于菌株类。

人正常结肠上皮细胞的培养操作规程及步骤!
HCoEpiC人正常结肠上皮细胞收到后的处理方法与培养操作规...
ATCC 33270 微小小单胞菌的培养与保存!
微小小单胞菌仅用于科学研究或者工业应用等非医疗目的不可用于人...

人脐静脉内皮细胞永生化接收后的处理方法与培养步骤!
人脐静脉内皮细胞永生化接收后的处理方法与培养步骤及注意事项。

ATCC 19707 海洋亚硝化球菌 百欧博伟生物
海洋亚硝化球菌,革兰氏阴性球形或拟球形细菌,专性化能无机营养...

小鼠颗粒细胞系的复苏与传代及冻存操作说明!
小鼠颗粒细胞系的复苏与传代及冻存操作说明!

树干毕赤酵母的培养方法与实验内容及打管说明!
树干毕赤酵母是Pichia属的微生物,原产地为中国。主要用途...